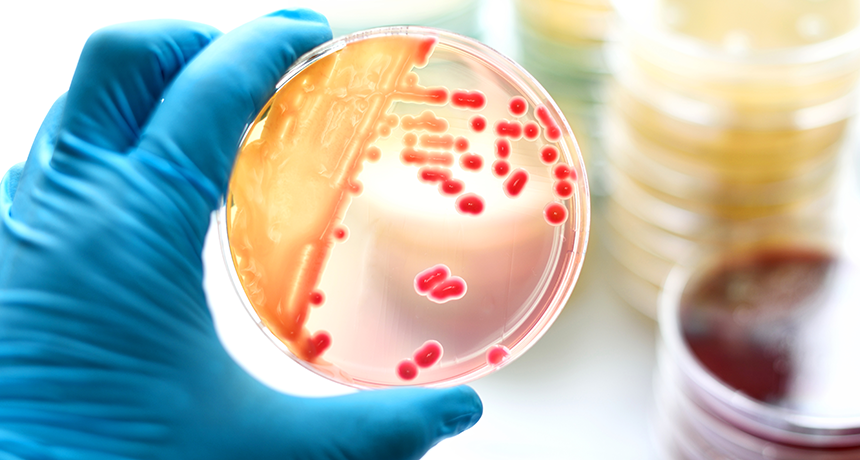
860_main_single_celled_world.png

Questions for ‘Bacteria are all around us — and that’s okay’
From the great outdoors to our internal organs, the world is awash in unseen bacteria (some seen growing on plate here). Most people assume (unfairly) that these germs are all dangerous. Biologists know better. Studying these poorly understood microbes could better reveal how they function as the "invisible backbone of life."
jarun011/iStockphoto